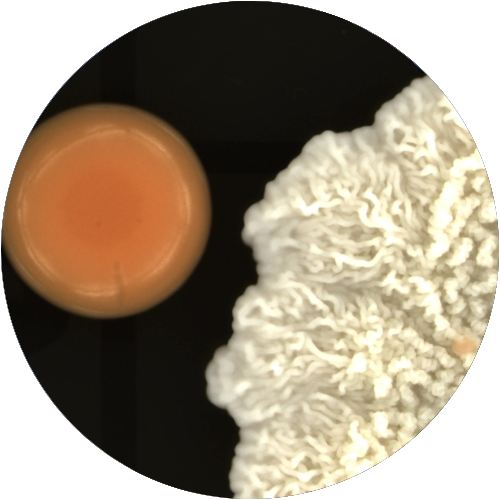

About us
Life at Singer Instruments
Weโre on a mission to accelerate research for scientists who want to make the world a better place.
Serving science for 90 years
We believe science shouldnโt be limited by whatโs humanly possible. It shouldnโt be frustratingly laborious or tedious and boring. From the climate crisis and renewable energy to antimicrobial resistance, cancer cures and unlocking the microbiome, science holds the key to many of the worldโs greatest challenges.
We hope our robots can get humanity there faster.
SINGER INSTRUMENTSโฆ A RESPONSIBILITY TO SCIENCE!
“Biology is the industry of nature. Itโs microscopic. Itโs renewable. Having evolved over billions of years, itโs way more sophisticated than human industrial endeavours. And we now understand it enough to be able to harness it and build with it. Inspired by nature, our customers are developing biological technologies that are making the world a better place.โ

Harry Singer
CEO
Our Story
Our company was founded in 1934, when your grandparents were probably still in nappies (diapers). Almost 90 years on and weโre still growing and thriving. Whatโs our secret? There is no secret. We listen. We collaborate. And we put our customers in the driving seat. The rest is history!
From our state-of-the-art facility in beautiful Exmoor National Park in the South West of England, we build and manufacture mechatronic workstations and cutting-edge lab automation robots accelerating science in over 60 countries worldwide. With further offices in California, Singapore and Germany, weโre able to serve a truly global community.
Our customers include Nobel laureates such as Sir Paul Nurse, world leading research facilities like EMBL and the Francis Crick Institute, and the top 50 universities in the world. Even NASA has joined the club (although they never did tell us what they were up to).
We design, manufacture, program, assemble and QC all of our products on site, giving us complete control over the product pipeline. This is all thanks to our in-house virtual prototyping facilities, precision CNC manufacture and robotic coordinate measurement for quality control. Youโll find no cheap imitations here.
What our customers say
โAs a long-time customer, I can say that it is really nice to have tools from Singer Instruments. This is quality equipment and if you have a problem, you know you can just email and someone will always respond.โ

Prof Joseph Schacherer,
Co-founder of the 1002 Yeast Genomes Project
โI canโt speak highly enough about these instruments. We have had them up and running for six months in our lab, and together, they have been a game-changer in terms of throughput and reproducibility.โ

Prof Kyle Lauersen,
Leader of the Sustainable & Synthetic Biology (SSB) group at King Abdullah University
A potted history
1934 – From a small workshop in Reading, UK, Arthur Singer founds a company manufacturing basic laboratory apparatus. Their technical expertise is diverted in WW2 to help make specialised components for radar and telecommunications.
1948 – Our first mechatronic instrument, the MK1 micromanipulator, is born. Demand spreads around the globe driving company expansion into a new premises.
1975 – Growing scientific interest in yeast as a model organism fueled by advances in genetic technology inspires a new business direction into tetrad dissection microscopes.
1979 – The company moves to Somerset where son Carl Singer later takes over as managing director. Collaboration with the genetics community grows, with Sir Paul Nurse later visiting to celebrate the opening of the companyโs new state-of-the-art robotics facility.
Company Values
When it comes to your science thereโs simply no time to waste. Ultimately, we exist to make your lab research easier. And we do this because we really believe in the importance of the scientific research you do!
We extend these values to our customers, products and services, employees, environment, surroundings, community, suppliers and anyone else with whom we are connected.
โCHARGEโ
as together we strive to bring cutting-edge microbial automation to agar plates everywhere!
COMMUNITY
We define success beyond profit. Our diverse work-life family and the scientific community we serve are at the core of everything we do.
HONESTY
We believe transparency, fairness, and simplicity builds trust and integrity. Itโs what makes us such a jolly nice bunch.
AUTHENTICITY
Weโre proud nerds and science punks and weโre not afraid to show it. The unique perspectives each of us brings helps us better serve our customers with genuine and reliable solutions. Only by being our true selves can we win trust.
RESPONSIBILITY
We believe we have a responsibility. To science. To the environment. To championing ED&I through our diverse workforce. To growing the employees of the future through our STEM Outreach work. And to supporting our communities to thrive.
GROWTH
Together we support our company and each other to grow. We see mistakes as learning opportunities and value ingenuity and innovation over process and pragmatism.
ENJOYMENT
Our ambition is to make the greatest impact while having the most fun. We take pride in our achievements and those of our customers. We play as hard as we work. Did someone say barbecue?

Happy Customers
2000+

Countries Served
60+

Year Founded
1934

Customer Satisfaction on
NPS Rating 76
Who we are
Singer Instruments strives to be Environmentally responsible, too!
Our Environmental strategy isn’t just a PR move. We’re actively striving towards NetZero
Singer Instruments UK Opening Times
Monday to Friday – 9am – 5pm GMT
Saturday and Sunday – Closed